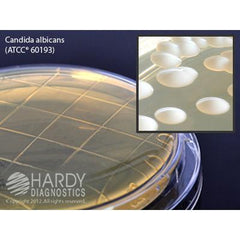
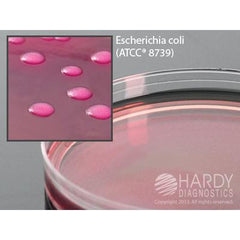

Media
Elevate your microbiology work with the best in culture media. Hardy Diagnostics offers a comprehensive selection of prepared plates, broths, and chromogenic formulas to support your critical research and testing.
- Extensive menu of classic and specialized media types
- Formulated for optimal growth of bacteria, fungi, and other microbes
- Manufactured in ISO-certified facilities under strict quality controls
- Backed by 60+ years of microbiology innovation and expertise
From routine identification to advanced microbiome studies, Hardy's culture media provide the reliable, consistent performance your lab demands. Invest in the quality and expertise of Hardy Diagnostics to get the superior results you need, time and time again.
41 - 55 of 55
- 1
- 2